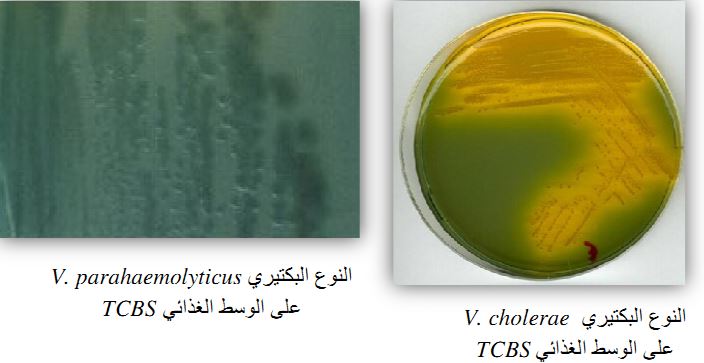
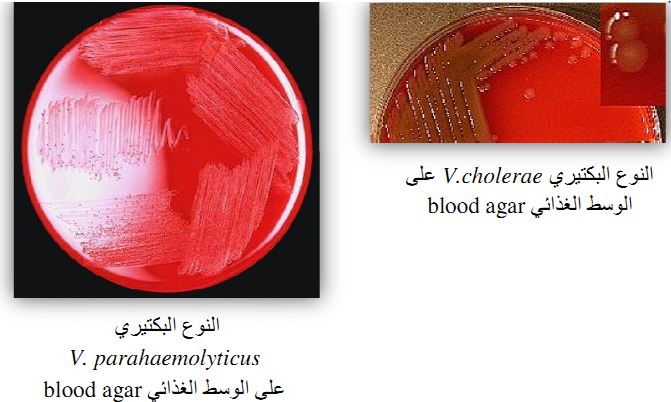

النبات

مواضيع عامة في علم النبات

الجذور - السيقان - الأوراق

النباتات الوعائية واللاوعائية

البذور (مغطاة البذور - عاريات البذور)

الطحالب

النباتات الطبية


الحيوان

مواضيع عامة في علم الحيوان

علم التشريح

التنوع الإحيائي

البايلوجيا الخلوية


الأحياء المجهرية

البكتيريا

الفطريات

الطفيليات

الفايروسات


علم الأمراض

الاورام

الامراض الوراثية

الامراض المناعية

الامراض المدارية

اضطرابات الدورة الدموية

مواضيع عامة في علم الامراض

الحشرات


التقانة الإحيائية

مواضيع عامة في التقانة الإحيائية


التقنية الحيوية المكروبية

التقنية الحيوية والميكروبات

الفعاليات الحيوية

وراثة الاحياء المجهرية

تصنيف الاحياء المجهرية

الاحياء المجهرية في الطبيعة

أيض الاجهاد

التقنية الحيوية والبيئة

التقنية الحيوية والطب

التقنية الحيوية والزراعة

التقنية الحيوية والصناعة

التقنية الحيوية والطاقة

البحار والطحالب الصغيرة

عزل البروتين

هندسة الجينات


التقنية الحياتية النانوية

مفاهيم التقنية الحيوية النانوية

التراكيب النانوية والمجاهر المستخدمة في رؤيتها

تصنيع وتخليق المواد النانوية

تطبيقات التقنية النانوية والحيوية النانوية

الرقائق والمتحسسات الحيوية

المصفوفات المجهرية وحاسوب الدنا

اللقاحات

البيئة والتلوث


علم الأجنة

اعضاء التكاثر وتشكل الاعراس

الاخصاب

التشطر

العصيبة وتشكل الجسيدات

تشكل اللواحق الجنينية

تكون المعيدة وظهور الطبقات الجنينية

مقدمة لعلم الاجنة


الأحياء الجزيئي

مواضيع عامة في الاحياء الجزيئي


علم وظائف الأعضاء


الغدد

مواضيع عامة في الغدد

الغدد الصم و هرموناتها

الجسم تحت السريري

الغدة النخامية

الغدة الكظرية

الغدة التناسلية

الغدة الدرقية والجار الدرقية

الغدة البنكرياسية

الغدة الصنوبرية

مواضيع عامة في علم وظائف الاعضاء

الخلية الحيوانية

الجهاز العصبي

أعضاء الحس

الجهاز العضلي

السوائل الجسمية

الجهاز الدوري والليمف

الجهاز التنفسي

الجهاز الهضمي

الجهاز البولي


المضادات الميكروبية

مواضيع عامة في المضادات الميكروبية

مضادات البكتيريا

مضادات الفطريات

مضادات الطفيليات

مضادات الفايروسات

علم الخلية

الوراثة

الأحياء العامة

المناعة

التحليلات المرضية

الكيمياء الحيوية

مواضيع متنوعة أخرى

الانزيمات
الجنس Vibeio cholerae
المؤلف:
عبد الرزاق سليمان التومي ، محمد محمد الامام ، عبد الباسط رمضان
المصدر:
اساسيات التشخيص البكتريولوجي المعملي والسريري
الجزء والصفحة:
17-7-2016
3618
Vibeio cholerae
هناك مجموعتين مصليتين serogroups من هذا النوع البكتيري وهما المسببتان لمرض الكوليرا ، وهم :
- المجموعة المصلية V. cholera O1
وهو يحتوي عدة أنواع حيوية biotypes كالتالي :
- الانواع الحيوية biotypes :
ــ El Tor وهو المسئول على أغلب إصابات الكوليرا الناتجه من النوع البكتيري V. cholerae O1
ــ Classical وهو على السلالات المتواجدة في الهند وبنغلاديش.
- الأنواع المصلي serotypes :
ــ Inaba .
ــ Ogawa
النوع المصلي Hikojima ناذر ، وهو يتصف بنفس صفات النوع المصلي Inaba والنوع المصلي Ogawa.
ويعتبر النوع V. cholerae O1 El Tor المسبب لوباء الكوليرا السابع الذي تفشى من إندونيسيا سنة 1961 ، ثم انتشر بسرعة إلى دولة بنغلاديش والهند وإيران والعراق، وفي سنة 1970 وصل مرض الكوليرا إلى غرب أفريقيا ومنها انتشر إلى شرق ووسط وجنوب القارة الأفريقية. في سنة 1991 وصل مرض الكوليرا إلى البيرو ومنها إلى جنوب ووسط أمريكا.
- المجموعة المصلية V. cholerae O139 (تسمى Bengal).
هذه المجموعة المصلية هي المسئولة عن الوباء epidemic الذي انتشر من البنغال سنة 1992 حتى وصل إلى الجنوب الشرقي لقارة أسيا والشرق الأقصى. تم رصد حالات الكوليرا الناتجة من الإصابة بالمجموعة البكتيرية V. cholerae في الصين والسعودية وإحدى عشر دولة أخرى في جنوب القارة الأسيوية ، كما بدأت معدلات الإصابة بالكوليرا الناتجة من الإصابة بهذه المجموعة المصلية في تزايد في دولتي بنغلاديش والهند مع العلم بأن هناك عدة أنواع مصلية أخرى من النوع البكتيري V. cholerae تسبب إسهال ولكنها ليست بسبب مرض الكوليرا. هناك انواع اخرى من الجنس البكتيري Vibrio مثل النوع البكتيري V. parahaemolyticus المسئول عن إحداث الإصابة عند تناول الأطعمة الملوثة في جنوب ــ شرق أسيا وخاصة في اليابان . والنوع البكتيري V. alginolyticus وهو انتهازي ويسبب التهابات الأذن والعين والجروح والنوع البكتيري V. vulnificus الذي يعتبر بكتيريا غازية ويسبب تعفن الدم Septicaemia خاصة في الأشخاص الذين يعانون من أمراض الكبد والاورام كما يمكن لهذا النوع البكتيري إحداث التهاب الجروح عند السباحة في المياه الملوثة او مناولة الحيوانات البحرية المصابة وقد يصل إلتهاب الجروح إلى تأكل الجلد والعضلات بعد تهيج الجرح. وهناك أنواع أخرى مثل النوع البكتيري V. mimicus المسئول عن النزلات المعوية والتهاب الأذن بعد السباحة في المياه الملوثة ، كما أن النوع البكتيري V. fluvialis يعتبر المسئول عن إحداث النزلة المعوية وإسهال شبيه بمرض الكوليرا cholera diaeehoea.

خريطة جغرافية توضح جائحات الكوليرا خلال الفترة ما بين سنة 1961 – 1971 .
الامراضية :
المجموعة المصلية V. cholerae O1 والمجموع المصلية V. cholerae O139 تسببان مرض الإسهال غير المصحوب بتهيج ، حيث يفرزان ذيفان معوي يعرف بذيفان الكوليرا (cholera toxin) والذي يتكون من وحدتين هما Subunits و subunits B الوحدة B ترتبط بمستقبل receptors متواجد على خلايا الأمعاء مما يسمح للوحيدة A بالدخول للخلايا وتنشيط الإنزيم adenylate cyclase الذي سيزيد من معدل cyclic adenosine monophosphate (cAMP) في الخلايا مما يؤدي لإفراز كمية كبيرة من السوائل والإلكترولايتات في تجويف الأمعاء وهو ما يجعل الإسهال مائي، ويتصف البراز الناتج عند الإصابة بمرض الكوليرا بأنه شبيه بماء الأرز (rice water stool).
في الطور الحاد من المرض يؤدي الفقدان السريع للسوائل والإلكترولايتات أثناء القيء والإسهال إلى التجفاف الحاد severe dehydration والذي إن لم يتم معالجته بسرعة فسيؤدي إلى الوفاة نتيجة الفشل الكلوي وصدمة نقص السوائل hypovolaemic shock العديد من الإصابات التي يحدثها هذا النوع البكتيري خفيفة ولا تتطور إلى أن تصل إلى أن تكون مرض الكوليرا الحاد. في الإصابات المتوطنة من مرض الكوليرا يكون الأطفال أكثر عرضة من البالغين.
وينتقل هذا النوع البكتيري واسطة تناول مياه ملوثة بالبراز الملوث، كما يمكن أن ينتقل من خلال الطعام الملوث مثل الأصداف البحرية غير المطهية والمأكولات البحرية الأخرى التي مصدرها مياه ملوث، حيث تعتبر الأصداف البحرية وكذلك العوالق البحرية عائل أساسي لهذا النوع البكتيري . تنتشر الأوبة التي يحدثها هذا النوع البكتيري في الاماكن المزدحمة كمعسكرات إيواء اللاجئين حيث يكون مصدر المياه غير آمن وعدم توفر شبكات الصرف الصحي كما أن بيئات معسكرات اللاجئين والأغذية في الغالب تكون غير آمنة.
وحيث أن فترة الحضانة لهذا النوع البكتيري قصيرة (ساعتين - 5 أيام) فإن معدلات الوفيات تكون عالية.
التشخيص المعملي :
النوع البكتيري V. cholerae يفضل النمو في درجة حرارة تتراوح ما بين 40-16 درجة مئوية بينما درجة الحرارة المثلى هي 37 درجة مئوية، كما تفضل النمو في وسط قلوي حيث الأس الهيدروجيني .2 PH . مع العلم بأن هذا النوع البكتيري غير محب للملوحة فليس له القدرة على النمو في وسط غذائي يحتوي على 10-6 % من كلوريد الصوديوم.
لتشخيص حالات الإصابة بمرض الكوليرا يتم تجميع عينة البراز للكشف المباشر علـــــــى مستضد هذا النوع البكتيري V. cholerae antigen ، وإجراء المزرعة البكتيرية ، في حال بعد مكان تجميع العينة عن معمل التحليل بحيث يتوقع بأن تصل بعد 24 ساعة، يتم استعمال وسط غذائي خاص بالنقل مثل الوسط الغذائي alkaline peptone water حيث أن هذا الوسط الغذائي يعتبر معنى لهذا النوع البكتيري وغير مناسب لنمو الأجناس البكتيرية المعوية الممرضة ، كما يمكن استعمال الوسط الغذائي Cary-Blair transport medium والذي يعتبر مناسب لعزل النوع البكتيري V. cholerae والأجناس البكتيرية المعوية الممرضة الاخرى.
يعتبر هذا النوع البكتيري سالباً صبغة جرام وغالباً ما تكون الخلايا عصوية منحنية curved rod، وتكون بحجم 4-3 X 0.5 ميكرومتر مع وجود سوط واحد على أحد الأطراف. يفضل استعمال carbon fuchsin المخفف (1 في 10) بدلاً من saffeanin في صبغة جرام ، مع العلم بأن المجموعة المصلية V. cholerae O1 تكون حافظة capsulated بعكس المجموعة المصلية V. cholerae O139 غير المكونة للحافظة .

ــ الوسط الغذائي (APW)ِAlkaline peptone water : تنمو مستعمرات النوع البكتيري V. cholerae بصورة جيدة في هذا الوسط الغذائي خلال 6-4 ساعات مكونة عكارة turbidity في على سطح الوسط الغذائي وفي الجزء المحاذي للسطح فقط ، ويعتبر هذا الوسط مغني كما ان حامضيته تمنع نمو البكتيريا التي تشكل الفلورا المعوية ويتم التأكد من أن المستعمرات النامية تتبع هذا النوع البكتيري يتم صبغها صبغة جرام.
ــ الوسط الغذائي Thiosulphate citrte bile salt sucrose agar (TCBS):
يفضل استعمال الوسط الغذائي المغني alkaline peptone المبدئي للنوع البكتيري V. cholerae إلا إذا كانت العينة تحتوي على عدد كبير من هذا النوع البكتيري ، يكون قطر المستعمرات النامية على هذا الوسط الغذائي حوالي 3-2 مم وهي مخمرة لسكر السكروز مما يجعل لونها أصفر بعد حضانتها لمدة 24 ساعة في درجة حرارة 37-35 درجة مئوية ، وهذه الصفات يمكن أن يظهرها أغلب سلالات النوع البكتيري V. fluvialis كما أن البكتيريا enterococci يمكن أن تنمو على هذا الوسط الغذائي مكونة مستعمرات بكتيرية صفراء صغيرة جداً كما يمكن للجنس البكتيري Aeromonas Spp النمو أيضاً على هذا الوسط الغذائي.
ــ الوسط الغذائي Blood agar : المستعمرات النامية للنوع البكتيري V. cholerae لها القدرة على الإحلال الكامل لكريات الدم الحمراء (B-haemolysis).
ــ الأوساط الغذائي المحتوية على أملاح الصفراوية bile salt : أغلب سلالات النوع البكتيري V. cholerae تنمو على الوسط الغذائي MacConkey على هيئة مستعمرات صغيرة غير مخمرة لسكر اللاكتوز بعد حضانتها لمدة 24 ساعة ومع مرور الوقت قد يتم تخمير سكر اللاكتوز كما أن هذا النوع البكتيري قد ينمو بصورة غير جيدة إن لم ينعدم النمو على الوسط الغذائي DCA agar والوسط الغذائي XLD agar .
الاختبارات المعملية :
من المهم جداً قبل إجراء الاختبارات الكيموحيوية وقبل إجراء الاختبارات المصلية للمستعمرات البكتيرية المخمرة لسكر السكروز (صفراء اللون) نقل هذه المستعمرات البكتيرية من الوسط الغذائي الانتقائي TCBS إلى وسط غذائي غير انتقائي mutrient agar حيث سيلاحظ بعد التحضين في درجة حرارة 37-35 درجة مئوية لمدة 6-4 ساعات ظهور نمو جيد في الجزء الأعلى من الإنبوبة Slope.
ــ اختبار الكشف على انزيم Oxidase : موجب (strong positive).
ــ اختبار الكشف تخمر سكر الآرابينوز L-arabinose : هذا الاختبار يساعد علــى التفريق بين النوع البكتيري V. cholerae والنوع البكتيري V. fluvialis حيث أن مستعمراتهم البكتيرية النامية على الوسط الغذائي TCBS تظهر بلون أصفر بينما النوع البكتيري V. fluvialis له القدرة على تخمير سكر الارابينوز.

كما هناك العديد من الاختبارات المصلية للتفريق بين النوع المصلي V. cholerae O139 (Bengal) ، والنوع المصلي V. vholerae (Inaba and Ogawa) .

النتيجة السالبة (الأعلى) والموجبة (الأسفل) لاختبار التجلط
 الاكثر قراءة في البكتيريا
الاكثر قراءة في البكتيريا
 اخر الاخبار
اخر الاخبار
اخبار العتبة العباسية المقدسة

الآخبار الصحية















 قسم الشؤون الفكرية يصدر كتاباً يوثق تاريخ السدانة في العتبة العباسية المقدسة
قسم الشؤون الفكرية يصدر كتاباً يوثق تاريخ السدانة في العتبة العباسية المقدسة "المهمة".. إصدار قصصي يوثّق القصص الفائزة في مسابقة فتوى الدفاع المقدسة للقصة القصيرة
"المهمة".. إصدار قصصي يوثّق القصص الفائزة في مسابقة فتوى الدفاع المقدسة للقصة القصيرة (نوافذ).. إصدار أدبي يوثق القصص الفائزة في مسابقة الإمام العسكري (عليه السلام)
(نوافذ).. إصدار أدبي يوثق القصص الفائزة في مسابقة الإمام العسكري (عليه السلام)


















